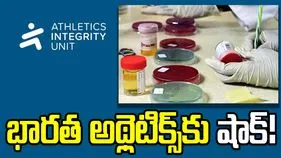
భారత్‌లో అత్యంత ప్రమాదకరంగా డోపింగ్ సమస్య.. ఏఐయూ కీలక ప్రకటన

హగ్ ఇచ్చిన ప్రీతి జింటా.. పంజాబ్ పేసర్ అర్ష్దీప్ సింగ్ రియాక్షన్ వైరల్
ABN , Publish Date - Apr 20 , 2026 | 08:37 PM
ఐపీఎల్ 2026లో పంజాబ్ కింగ్స్ జట్టు అజేయంగా దూసుకెళ్తోంది. అయితే ఆదివారం లఖ్నవూ సూపర్ జెయింట్స్పై పంజాబ్ ఘన విజయం సాధించిన విషయం తెలిసిందే. మ్యాచ్ అనంతరం జరిగిన ఓ సరదా సన్నివేశం ఇప్పుడు సోషల్ మీడియాలో తెగ వైరల్ అవుతోంది.

ఇంటర్నెట్ డెస్క్: ఐపీఎల్ 2026లో పంజాబ్ కింగ్స్ జట్టు అజేయంగా దూసుకెళ్తోంది. ఆడిన అన్ని మ్యాచుల్లోనూ గెలిచి పాయింట్ల పట్టికలో అగ్రస్థానంలో కొనసాగుతోంది. ఆదివారం లఖ్నవూ సూపర్ జెయింట్స్పై పంజాబ్ ఘన విజయం సాధించిన విషయం తెలిసిందే. అయితే మ్యాచ్ అనంతరం జరిగిన ఓ సరదా సన్నివేశం ఇప్పుడు సోషల్ మీడియాలో తెగ వైరల్ అవుతోంది. పంజాబ్ కింగ్స్ కో ఓనర్, బాలీవుడ్ బ్యూటీ ప్రీతి జింటా ఎల్ఎస్జీ మ్యాచ్లో సందడి చేసింది. మ్యాచ్ అనంతరం స్టార్ పేసర్ అర్ష్దీప్ సింగ్కు మైదానంలో హగ్ ఇచ్చింది.
జట్టు విజయంలో కీలక పాత్ర పోషించిన ప్లేయర్లకు ప్రీతి జింటా హగ్ ఇస్తుంటుంది. ఒకప్పుడు పంజాబ్ జట్టుకు ఆడిన యువరాజ్ సింగ్, క్రిస్ గేల్ వంటి దిగ్గజాలకు కూడా ప్రీతి హగ్ ఇచ్చింది. తన పిల్లలను చూసుకోవడంలో బిజీగా ఉన్న ఆమె.. ఈ సీజన్లో కొన్ని మ్యాచ్లకు హాజరుకాలేదు. ఆదివారం లఖ్నవూతో జరిగిన మ్యాచులో వచ్చి సందడి చేసింది. మ్యాచ్ అయ్యాక మైదానంలోకి వచ్చి ఆటగాళ్లను అభినందించింది. ఈ క్రమంలోనే అర్ష్దీప్ సింగ్ను హగ్ చేసుకుంది. అంతే హగ్ తీసుకున్న వెంటనే అతడు ఎగిరి గంతేశాడు. అతడి సరదా స్టెప్స్ చూసి ప్రీతి జింటా సహా అక్కడున్న వారంతా నవ్వేశారు. ఈ దృశ్యాన్ని చూసిన ఎల్ఎస్జీ పేసర్ షమి కూడా చిరునవ్వు చిందించడం నెట్టింట వైరల్గా మారింది.
ఇక మ్యాచ్ విషయానికి వస్తే, పంజాబ్ కింగ్స్ మరో అద్భుత విజయం సాధించింది. లఖ్నవూ సూపర్ జెయింట్స్పై 54 పరుగుల తేడాతో గెలిచింది. ముందుగా బ్యాటింగ్ చేసిన పంజాబ్ 20 ఓవర్లలో 7 వికెట్లు కోల్పోయి ఏకంగా 254 పరుగుల భారీ స్కోర్ నమోదు చేసింది. ఇది ఈ సీజన్లో అత్యధిక జట్టు స్కోర్గా నిలిచింది. ఓపెనర్ ప్రియాంశ్ ఆర్య(93) అదరగొట్టాడు. మరోవైపు కూపర్ కానోలి(87) మెరిశాడు. వీరిద్దరూ కలిసి రెండో వికెట్కు ఏకంగా 182 పరుగుల భాగస్వామ్యాన్ని నెలకొల్పారు. ఛేదనలో లఖ్నవూ జట్టు 200 పరుగులకే పరిమితం అయింది.
ఇవి కూడా చదవండి:
ఐపీఎల్ 2026: ముంబై ఇండియన్స్తో మ్యాచ్.. టాస్ నెగ్గిన గుజరాత్ టైటాన్స్
సిక్సర్ల పిడుగు వైభవ్ సూర్యవంశీ మళ్లీ ఏడ్చేశాడు.. వీడియో వైరల్